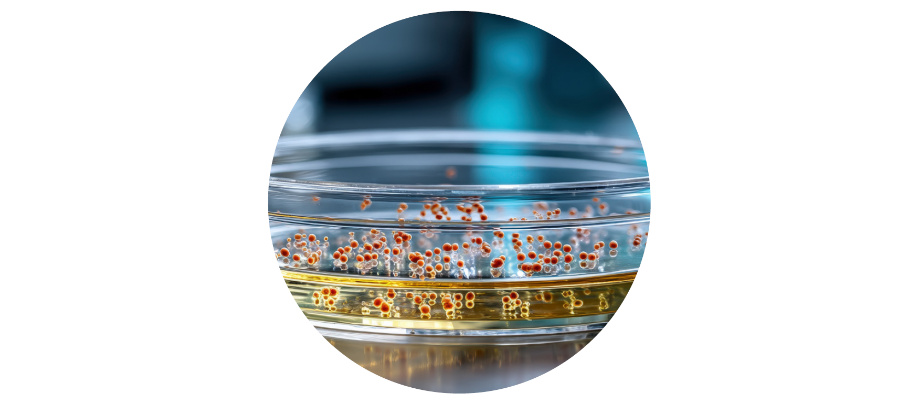
target 920*400

Projet TRANSFORMATION - TARGET
Fiche d'identité du projet TARGET
Titre : Cultiver l’incultivable : accéder à une galaxie microbienne inexplorée
Porteur : Pascal SIRAND-PUGNET, Professeur Université de Bordeaux, Unité Biologie du Fruit & Pathologie (INRAE, Université de Bordeaux)
Partenaires :
- Yves GIBON, Directeur de Recherche INRAE, Unité Biologie du Fruit & Pathologie (INRAE, Université de Bordeaux)
- Clémence FRIOUX, Chargée de Recherche Inria, Equipe PLEÏADE (INRAE, Inria, Université de Bordeaux)
- Christophe MOUGEL, Directeur de Recherche INRAE, Institut de Génétique Environnement et Protection des Plantes (INRAE, Institut Agro Rennes Angers, Université de Rennes)
Durée : 48 mois
Démarrage : Septembre 2025
Montant : 2 M€
Contact : pascal.sirand-pugnet [at] inrae.fr
Et si on pouvait enfin cultiver des bactéries jusqu’alors incultivables en laboratoire ?
Les récentes technologies de séquençage haut débit révèlent l’existence de millions d’espèces de bactéries dans tous les écosystèmes ou vivant en association avec des organismes plus complexes comme les humains, les autres animaux et les plantes. Malgré les efforts des microbiologistes depuis la fin du XIXe siècle, la proportion d’espèces bactériennes cultivées en laboratoire reste réduite. Ce mystère scientifique freine de nombreux progrès en santé, agriculture ou environnement.
Le projet TARGET veut lever ce verrou grâce à une combinaison inédite de technologies : modélisation du métabolisme, biologie des systèmes, ciseaux moléculaires et dispositifs miniaturisés de culture. La preuve de concept sera faite sur un ennemi des vignerons : le phytoplasme de la flavescence dorée, une bactérie au génome réduit qui se multiplie exclusivement à l’intérieur des cellules de son hôte, responsable de lourdes pertes dans le vignoble français. Jusqu’ici incultivable, elle pourrait, grâce à TARGET, enfin être isolée et étudiée en laboratoire.
Ce serait une première mondiale aux conséquences majeures : développer de nouvelles méthodes de lutte contre d’autres bactéries pathogènes non cultivées et ouvrir des pistes dans la recherche d’antibiotiques, la dépollution ou la manipulation des microbiotes. À l’heure du changement climatique et de l’émergence de nouvelles maladies, TARGET pourrait bien changer les règles du jeu.
